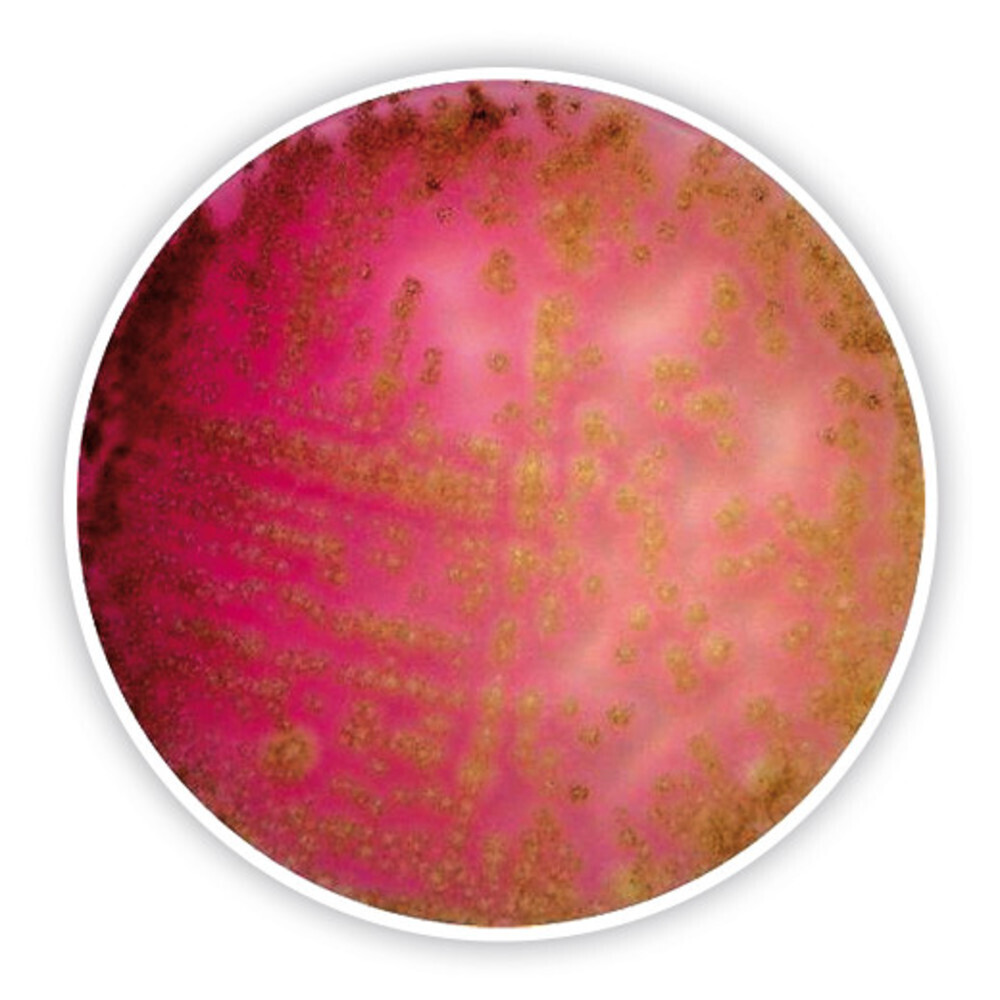
Dichlorane Bengal Red Agar (with chloroamphenicol)

Verzending 24–48 u • Levering in de hele EU • Veilige chemieverpakking
Dichlorane Bengal Red Agar (with chloroamphenicol)
SKU AE25.1
€ 217,42
In stock
1
Save this product for later
Dichlorane Bengal Red Agar (with chloroamphenicol)
Product Details
HS code: 38210000
Brand: Carl Roth
Dichlorane Bengal Red Agar,chloramphen., ISO 11133, ISO 21527-1, for microbiology, Storage temp. +15 to +25 °C
You May Also Like
End user declaration required

Sodium chlorite 25% 5 Liter
Sodium chlorite 25% 5 Liter
Only for registered companies
SKU NCL91.1.2
€ 52,92
Out of stock
End user declaration required

Dichloromethane 99,5+%, pure 5 Liter in metalen blik
Dichloromethane 99,5+%, pure 5 Liter in metalen blik
Only for registered companies
SKU DCM1.1.3
€ 48,69
Display prices in:EUR